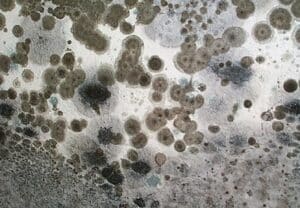

seleccione el idioma

Do you need to identify the source of a leak in your home? From broken waterlines to a clogged toilet, AAA AUGER Plumbing Services will find and stop it all with just one call. We specialize in leak detection services for both residential and commercial plumbing systems. We are a full service, licensed and insured plumbing and leak detection company serving the greater DFW area including Austin and San Antonio.

Do You Suspect a Leak in Your Home or Business?
There are many different ways that a home or business owner can find out if they have a plumbing leak. Some people may hear the telltale sound of water running even when all fixtures are turned off. Others may see water stains on the ceiling or walls, which can be a sign of a hidden plumbing leak. Still, others may notice an increase in their water bill even though their usage hasn’t changed.
If you suspect you have a plumbing leak, it’s important to act quickly to avoid any further damage to your property. A professional leak detection and repair service can help you locate the source of the leak and make the necessary repairs. At AAA AUGER Plumbing Services, we have decades of experience helping home and business owners with their plumbing needs, including leaks. We use cutting-edge technology to quickly and accurately locate leaks, and our skilled technicians will make the necessary repairs to get your system back up and running smoothly.
Leaks Deserve Professional Attention
If your home is in need of plumbing repair, it may be tempting to try and fix the problem yourself. However, unless you are a professional plumber, it is likely that any repairs you make will only be temporary fixes. Calling a professional plumber at AAA AUGER Plumbing Services is one of the best ways to ensure that your plumbing repair is done correctly and will last.
There are many people who are skeptical of calling a plumber because they believe that it is too expensive. However, the cost of having a professional plumber come to your home and fix the problem is likely to be much less than the cost of repairing the damage yourself. In addition, if you try to repair the problem yourself and something goes wrong, you may end up causing even more damage which will end up costing you even more money.

It is important to remember that when it comes to plumbing repairs, it is always better to call a professional. Trying to repair the problem yourself is not only more likely to cause further damage, but it is also more likely to be ineffective in actually fixing the problem.
Trust Us with Your Leak Detection and Repiping Needs
At AAA AUGER Plumbing Services, we have the experience and the know-how to quickly and accurately detect leaks in your plumbing system – no matter how big or small. We also use the latest technology to handle any sewer line repair or replacement needs you may have. When it comes to your home or businesses’ plumbing, you can trust AAA AUGER Plumbing Services to get the job done right – and at a price that is fair and honest.
If you suspect you have a plumbing leak, don’t hesitate to contact AAA AUGER Plumbing Services for professional assistance. We’re available 24/7 to take your call, and we offer competitive pricing and friendly service. For more info, please browse our website at: https://auger.blogdiversity.com.